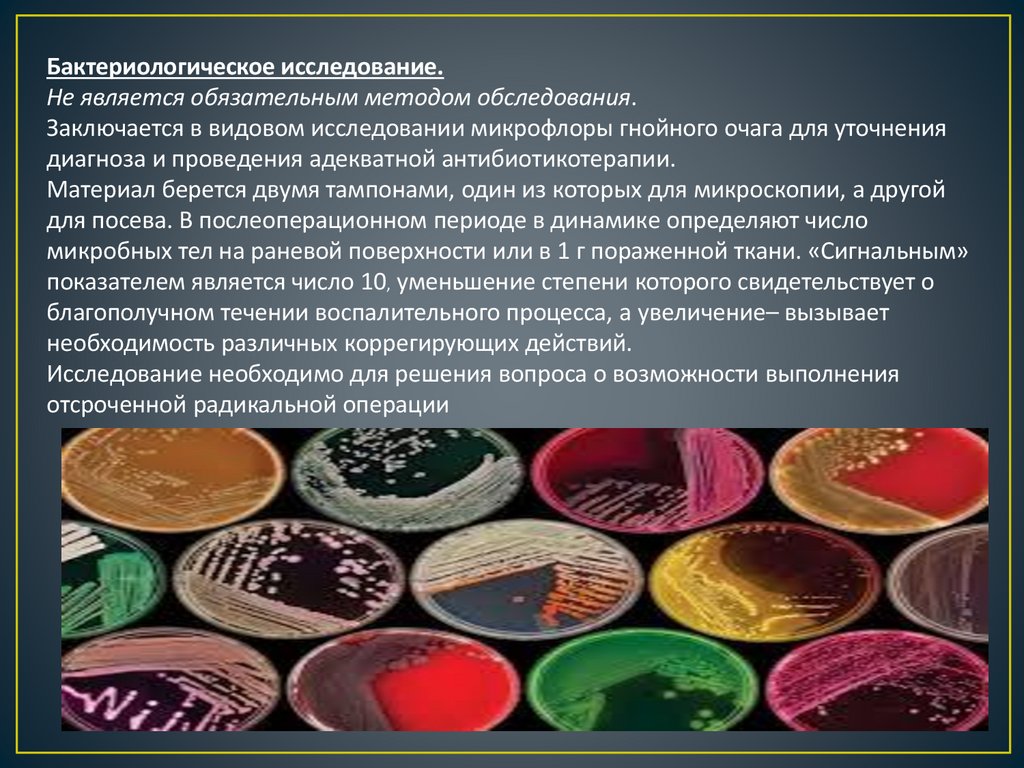

Similar presentations:
Заболевания прямой кишки
1.
2.
3.
АНАТОМИЯ ПРЯМОЙ КИШКИ4.
Анальная трещина — спонтанно возникающий линейный илиэлипсовидный дефект (язва) слизистой оболочки анального канала.
Ведущим патогенетическим механизмом в развитии анальной трещины
является спазм внутреннего сфинктера, который приводит к нарушению
кровоснабжения анодермы и появлению длительно незаживающего
язвенного дефекта анодермы.
5.
Анальная трещина одно из самых распространенныхколопроктологических заболеваний. Удельный вес трещины
заднего прохода среди болезней толстой кишки составляет
11—15%, а заболеваемость колеблется от 20 до 23 на 1000
человек взрослого населения .
6.
КЛАССИФИКАЦИЯПо характеру течения выделяют:
- Острую анальную трещину
- Хроническую анальную трещину
По локализации дефекта выделяют:
- Заднюю анальную трещину;
- Переднюю анальную трещину
- Боковую анальную трещину
По наличию спазма сфинктера выделяют
-Со спазмом сфинктера;
- Без спазма сфинктера
7.
Жалобы: на боли в области заднего прохода во время ипосле дефекации, выделения крови во время дефекации в
виде помарок на стуле и туалетной бумаге .
Осмотр: пациента осматривают на гинекологическом
кресле, в положении на спине с максимально
приведенными к животу ногами, или в коленно-локтевом
положении. У соматически тяжелых больных осмотр
производят в положении на боку. При наружном осмотре
области промежности и заднего прохода обращают
внимание на форму ануса, его зияние, наличие рубцовых
изменений и деформаций, состояние кожных покровов.
8.
Пальцевое исследование: Определяется наличие дефектованодермы, а так же тоническое состояние анального
сфинктера и сила волевых сокращений. Выявляется
характерное для анальной трещины повышение тонуса
сфинктера.
Аноскопия, ректороманоскопия, колоноскопия: проводятся
после купирования болевого синдрома.
Функциональные исследования запирательного аппарата
прямой кишки. Профилометрия – метод оценки давления в
просвете полого органа при протягивании измерительного
катетера. Аноректальная профилометрия обеспечивает
регистрацию давления в разных плоскостях по всей длине
анального канала. У всех пациентов с анальной трещиной
имеются хотя бы один из манометрических признаков спазма
внутреннего сфинктера .
9.
Острая анальная трещина:- Заболевание длиться менее 3-х месяцев.
- Отсутствуют рубцовые изменения в области краев и дна
анальной трещины.
Хроническая анальная трещина:
- Длительность заболевания с момента первого эпизода
болевого синдрома более 3-х месяцев.
- Сторожевой бугорок.
- Рубцовые края.
- Наличие волокон внутреннего сфинктера в дне дефекта.
- Фиброзный полип анального канала.
10.
ЛЕЧЕНИЕ АНАЛЬНОЙ ТРЕЩИНЫ1. КОНСЕРВАТИВНАЯ ТЕРАПИЯ (не более 6 недель)
Показания: Острая анальная трещина. Включает теплые сидячие ванночки и
послабляющие средства (препараты содержащие пищевые волокна в виде
оболочек семян подорожника: «Фитомуцил», «Мукофальк», «Метамуцил»,
«Файберлекс») позволяет купировать болевой синдром, добиться остановки
кровотечений и заживления у 50% больных острой анальной трещиной с
минимальным риском развития побочных эффектов .
Противопоказания: Эрозивно-язвенные поражения верхних отделов желудочнокишечного тракта; Нарушения проходимости кишечника; Онкологические
заболевания с локализацией поражения в области малого таза.
2.КОНСЕРВАТИВНАЯ ТЕРАПИЯ В СОЧЕТАНИИ С МЕДИКАМЕНТОЗНОЙ РЕЛАКСАЦИЕЙ
ВНУТРЕННЕГО СФИНКТЕРА ПРЯМОЙ КИШКИ.
Показания: Острая и хроническая анальная трещина. При хронической анальной
трещине в схему консервативной терапии следует включать препараты для
медикаментозной релаксации внутреннего сфинктера прямой кишки .
В качестве препаратов первой линии применяют органические нитраты.
- Нитроглицериновая мазь 0,4%, Крем дилтиазема 2%, нифедипина 0,3%
(осложнения-головная боль)
- Ботокс (ботулинический токсин типа А). Вводится во внутренний сфинктер по обе
стороны от анальной трещины в дозе 10-100 Ед. (осложнения – недержание газов,
кишечного содержимого).
11.
Противопоказания для проведения консервативной терапии хронической анальнойтрещины:
- Выпадение фиброзного полипа из анального канала или наличие фиброзного
полипа более 1 см в диаметре.
- Пектеноз - ригидное сужение заднего прохода за счет фиброзных изменений
внутреннего сфинктера прямой кишки вследствие его длительного спазма и
нарушения кровообращения .
При наличии указанных симптомов консервативное лечение не проводится, сразу
переходят к хирургическому лечению.
3. ХИРУРГИЧЕСКОЕ ЛЕЧЕНИЕ ХРОНИЧЕСКОЙ АНАЛЬНОЙ ТРЕЩИНЫ.
Включает в себя различные методы хирургической релаксации внутреннего
сфинктера прямой кишки.
Показания: неэффективность консервативной терапии.
1. Боковая подкожная сфинктеротомия.
2. Контролируемая пневмодивульсия анального сфинктера.
3. Иссечение трещины в сочетании с медикаметозной релаксацией внутреннего
сфинктера.
12.
13.
Геморрой является одним изсамых распространенных
заболеваний человека и наиболее
частой причиной обращения к
врачу-колопроктологу.
Распространённость заболевания
составляет 130-145 человек на 1000
взрослого населения, а его
удельный вес в структуре
заболеваний толстой кишки
колеблется от 34 до 41 %.
Геморрой - патологическое увеличение
геморроидальных узлов . Комбинированный
геморрой – увеличение одновременно наружных
и внутренних геморроидальных узлов .
14.
Причиной патологического увеличения геморроидальных узлов является :- Острое или хроническое нарушение кровообращения в кавернозных образованиях.
- Дистрофические изменения в связочном аппарате геморроидальных узлов.
Под действием перечисленных факторов геморроидальные узлы
увеличиваются в размерах, смещаются в дистальном направлении, при этом нарастают
процессы дистрофии в удерживающем аппарате, и геморроидальные узлы начинают
выпадать из анального канала.
Развитие дистрофических процессов в общей продольной мышце
подслизистого слоя прямой кишки и связке Паркса, удерживающих кавернозные тельца
в анальном канале, приводит к постепенному, но необратимому смещению
геморроидальных узлов в дистальном направлении.
15.
КЛАССИФИКАЦИЯФорма:
1. Внутренний
2. Наружный
3. Комбинированный
Течение: 1. Хроническое 2. Острое
Острое
течение
Степени
1
2
3
Симптоматика
Тромбоз
узлов
без
воспалительной реакции
Тромбоз узлов с их воспалением
Тромбоз узлов с их воспалением
и переходом воспаления на
подкожную клетчатку, отеком
перианальной кожи, некрозом
слизистой оболочки узлов
Под острым течением заболевания также понимается профузное, обильное
кровотечение из внутренних геморроидальных узлов, требующее срочной
госпитализации пациента в стационар
16.
Хроническоетечение
Степени
Симптоматика
1
Кровотечение, без выпадения узлов
2
Выпадение внутренних геморроидальных узлов с
самостоятельным вправлением в анальный канал,
с/без кровотечения
3
Выпадение внутренних геморроидальных узлов с
необходимостью их ручного вправления в
анальный канал, с/без кровотечения
4
Постоянное
выпадение
внутренних
геморроидальных узлов и невозможность их
вправления
в
анальный
канал,
с/без
кровотечения
17.
ДИАГНОСТИКАК основным клиническим симптомам острого геморроя относятся:
- боли в области заднего прохода и прямой кишки,
- появление плотного болезненного образования (ий) в области расположения
наружных и/или внутренних геморроидальных узлов,
- профузное обильное выделение крови из прямой кишки, не останавливающееся с
помощью консервативных мероприятий (свечи, мази, местное применение
холода, флеботропные препараты и т.п.).
При развитии воспалительных осложнений острого тромбоза
геморроидальных узлов с переходом воспалительного процесса на окружающие
ткани, параректальную клетчатку возможно появление общих воспалительных
симптомов, таких как повышение температуры тела, лихорадка.
К основным клиническим симптомам хронического геморроя относятся:
- выпадение внутренних геморроидальных узлов из заднего прохода при
дефекации,
- выделение крови из заднего прохода при дефекации (примесь алой крови к стулу,
выделение крови в виде капель или струйки),
- наличие увеличенных наружных геморроидальных узлов,
- чувство дискомфорта , зуд, жжение в области заднего прохода.
Болевые ощущения при хроническом геморрое встречаются редко и, как
правило, связаны с осложнениями заболевания (тромбоз наружных и/или
внутренних геморроидальных узлов) или появлением анальной трещины, свища
прямой кишки.
18.
Оценка анального рефлекса. Выполняется штриховое раздражение кожиперианальной области для определения рефлекторных сокращений анального
сфинктера.
Пальцевое исследование прямой кишки. Определяется тоническое состояние
анального сфинктера и сила волевых сокращений, болезненность при
исследовании, наличие дефектов слизистой анального канала, объемных
образований анального канала и прямой кишки .
Аноскопия. Осматривается анальный канал и дистальная часть прямой кишки,
оценивается расположение и степень выраженности внутренних геморроидальных
узлов, состояние слизистой оболочки, покрывающей внутренние геморроидальные
узлы, зубчатая линия с анальными криптами, состояние слизистой
нижнеампулярного отдела прямой кишки.
Ректороманоскопия (до 25 см) Диагностика сопутствующих заболеваний прямой и
сигмовидной кишки.
Колоноскопия и ирригоскопия. Диагностика сопутствующих изменений толстой
кишки, исключение воспалительных изменений характерных для язвенного колита
и болезни Крона. Колоноскопия или ирригоскопия показана с целью исключения
новообразований толстой кишки всем пациентам старше 50 лет
Исследование функционального состояния запирательного аппарата прямой
кишки (профилометрия, сфинктерометрия, электромиография). Показано перед
операцией у больных с изначальными клиническими признаками нарушения
функции анального сфинктера.
19.
КОНСЕРВАТИВНОЕ ЛЕЧЕНИЕНаправлено на нормализацию деятельности желудочно-кишечного
тракта и устранение запоров, с помощью потребления адекватного количества
жидкости и пищевых волокон.
В качестве источника пищевых волокон традиционно применяют
пшеничные отруби, морскую капусту и льняное семя в их природном виде, или в
форме фармакологических препаратов, семена и шелуху подорожника
(мукофальк, фитомуцил), обладающих высокой водоудерживающей
способностью, что позволяет избегать натуживания при дефекации.
Однако, только консервативная терапия, направленная на
нормализацию деятельности желудочно-кишечного тракта,
не является самостоятельным эффективным методом
лечения геморроя, особенно при 3-4 стадии
20.
Фармакотерапия острого и хронического геморроя преследует следующие цели :1. купирование симптомов острого геморроя;
2. предотвращение осложнений;
3. профилактика обострений при хроническом течении;
4. подготовка больного к операции;
5. послеоперационная реабилитация.
При болевом синдроме показано применение ненаркотических анальгетиков
и местных комбинированных обезболивающих препаратов в виде гелей, кремов, мазей
и суппозиториев (Проктозан, Ауробин, Ультрапрокт, Прокто-гливенол, Постеризан,
Релиф Адванс, Нефлуан, Эмла ).
При тромбозе геморроидальных узлов показано применение
антикоагулянтов местного действия (мазевые основы содержащие гепарин, мазь с
троксерутоном).
При тромбозе геморроидальных узлов, осложненном воспалением
окружающих мягких тканей (в случае если исключен гнойно-воспалительный процесс),
показано использование комбинированных препаратов содержащих обезболивающие,
тромболитические и противовоспалительные компоненты (Проктоседил, Ауробин,
Прокто-гливенол, Проктозан, Гепатромбин), а также комбинированных
флеботонических препаратов (Детралекс, Флебодия, Гинкор Форте, Цикло-3-форте,
Гливенол, Троксерутин).
21.
Для купирования воспаления и обезболивания применяют топическиепрепараты и НПВС с комбинированным действием (Ксефокам, Кетопрофен,
Диклофенак, Вольтарен, Индометацин).
При геморроидальных кровотечениях возможно использование местных
препаратов в виде суппозиториев (Натальсид, Релиф, свечи содержащие
адреналин), а также системных флеботонических (Детралекс, Флебодия) и
гемостатических препаратов (Этамзилат, Тронексам).
22.
МАЛОИНВАЗИВНЫЕ ХИРУРГИЧЕСКИЕ МЕТОДЫ ЛЕЧЕНИЯПоказания:
– неэффективность консервативной терапии
- геморой 1-3 ст
1. Склерозирование внутренних геморроидальных узлов
Показания: 1-3 стадии кровоточащего геморроя; наибольшая эффективность метода
отмечается при кровоточащем геморрое 1-2 стадии.
Противопоказания : острый геморрой, острый парапроктит, анальная трещина.
Эффективность данного метода составляет 75-89%.
2. Инфракрасная фотокоагуляция геморроидальных узлов
Показания: кровоточащий геморрой 1-2 стадии.
Противопоказания: воспалительные заболевания аноректальной области и
промежности.
Эффективность метода составляет 60-70%.
23.
24.
3. Лигирование геморроидальных узлов латекснымикольцами .
Показания: 2-3 стадии геморроя с наличием отдельно
расположенных внутренних геморроидальных узлов с четкими
границами .
Противопоказания: циркулярный геморрой, отсутствие четких
границ между наружным и внутренним компонентом, анальная
трещина, свищи прямой кишки.
Считается эффективным методом малоинвазивного
лечения геморроя, имеет низкий процент рецидивов. Однако
характерен интенсивный болевой синдром , имеется риск
возникновения тромбоза наружных геморроидальных узлов и
в редких случаях могут встречаться воспалительные
осложнения .
25.
26.
4. Дезартеризация геморроидальных узлов под контролемультразвуковой допплерометрии
Показания: геморрой 2-4 стадии.
Противопоказания: воспалительные заболевания аноректальной области и
промежности.
Эффективность методики составляет 81% у пациентов с 2-3 стадией
геморроя. После операции не требуется проведение антибактериальной
терапии и использование наркотических анальгетиков.
5. Дезартеризация геморроидальных узлов с мукопексией
Показания: геморрой 2-4 стадии.
Противопоказания: воспалительные заболевания аноректальной области и
промежности.
В настоящее время дезартеризация геморроидальных узлов с
мукопексией является наиболее эффективным и безопасным методом
лечения больных со 2-3 стадией геморроя .
27.
28.
29.
ХИРУРГИЧЕСКОЕ ЛЕЧЕНИЕГеморроидэктомия показана пациентам при 3-4 стадии заболевания с
выраженными наружными геморроидальными узлами, при неэффективности или
невозможности применения малоинвазивных хирургических методов . Один из
самых эффективных методов лечения. Высокая частота осложнений.
1. Закрытая геморроидэктомия (с восстановлением слизистой оболочки
анального канала) Применяется при отсутствии четких границ между
наружным и внутренним геморроидальными узлами .
2. Открытая геморроидэктомия. Применяется у пациентов с 3-4 стадией
заболевания как отдельный метод, а также в случаях сочетания геморроя с
наличием воспалительных заболеваний анального канала (анальная трещина,
свищ прямой кишки (операция Милигана-Моргана)
3. Подслизистая геморроидэктомия. Методика позволяет без деформации и
натяжения полностью восстановить слизистую оболочку анального канала и
прямой кишки с подслизистым расположением культи узла. В связи с
повышенной кровоточивостью тканей при подслизистом выделении
кавернозной ткани операция сопровождается техническими сложностями.
4. Степлерная геморроидопексия (операция Лонго) Показанием к применению
метода является геморрой 3-4 стадии, а так же сочетание геморроя с
выпадением слизистой оболочки нижнеампулярного отдела прямой кишки.
30.
31.
32.
Осложнения.1. Кровотечение
2. Тромбоз геморроидадьных узлов
3. Воспалительный процесс, развившийся в окружающей клетчатке в результате
тромбоза геморроидальных узлов.
4. На поздних стадиях заболевания осложнениями являются зуд и трещины заднего
прохода.
33.
Острый парапроктит – острое воспаление околопрямокишечнойклетчатки, обусловленное распространением воспалительного процесса
из анальных крипт и анальных желез.
Острый парапроктит является самым распространенным заболеванием в
практике неотложной хирургической проктологии. Пациенты этой группы
составляют около 1% всех госпитализированных в различные стационары
хирургического профиля и 5% среди страдающих заболеваниями
ободочной и прямой кишок. В числе острых гнойных поражений
аноректальной зоны, частота ОП приближается к 45%.
Этиология.
Развитие ОП обусловлено рядом предрасполагающих факторов:
ослабление иммунитета вследствие сопутствующей острой или
хронической инфекции, сосудистые изменения вследствие сахарного
диабета, желудочно-кишечные расстройства, наличие геморроя, трещин,
криптита.
34.
35.
Классификация острого парапроктита.I. По характеру возбудителя:
1. Аэробный.
2. Анаэробный:
- клостридиальный;
- неклостридиальный.
II. По локализации поражения:
а) подкожный;
б) подслизистый;
в) межмышечный;
г) седалищно-прямокишечный (ишиоректальный);
д) тазово-прямокишечный:
- пельвиоректальный;
- ретроректальный;
- подковообразный.
36.
37.
III. По локализации крипты, вовлеченной в процесс воспаления:А. Задний.
Б. Передний.
В. Боковой.
IV. По характеру гнойного хода:
а) интрасфинктерный;
б) транссфинктерный;
в) экстарсфинктерный.
38.
ДИАГНОСТИКА ЗАБОЛЕВАНИЯ.Диагностика острого парапроктита основана на жалобах
больного, степени их выраженности, длительности болезни,
анализе результатов клинического и объективного
обследования пациента.
К основным клиническим проявлениям ОП относятся: острое
начало заболевания, нарастающая боль в прямой кишке,
промежности или в тазу, повышение температуры тела.
39.
Осмотр больного.Проводят на гинекологическом кресле в положении на спине или в коленолоктевом положении. При этом оценивают гиперемию, припухлость кожных
покровов перианальной, крестцово-копчиковой области и ягодиц, наличие резко
болезненного инфильтрата или флюктуации в этой области. При осмотре
промежности и заднего прохода выявляют патологические выделения гноя или
слизи, сопутствующие заболевания - анальная трещина, геморрой, свищи или
выпадение прямой кишки .
Пальцевое исследование прямой кишки.
Этот диагностический прием является основным при остром парапроктите и
несет определяющую информацию при сложных разновидностях заболевания:
- выявляют болезненность одной из стенок прямой кишки,
- тестоватую консистенцию и инфильтрацию кишечной стенки или плотный
инфильтрат за её пределами,
- определяют утолщение стенки кишки, оттеснение её извне, выбухание в
просвет эластичной, иногда флюктуирующей, опухоли, над которой слизистая
оболочка кишки может оставаться подвижной.
Фистулография.
Не является обязательным методом обследования, используют для уточнения
диагноза.
Определяется расположение и размеры гнойной полости, ход свища по
отношению к наружному сфинктеру.
40.
Бактериологическое исследование.Не является обязательным методом обследования.
Заключается в видовом исследовании микрофлоры гнойного очага для уточнения
диагноза и проведения адекватной антибиотикотерапии.
Материал берется двумя тампонами, один из которых для микроскопии, а другой
для посева. В послеоперационном периоде в динамике определяют число
микробных тел на раневой поверхности или в 1 г пораженной ткани. «Сигнальным»
показателем является число 10, уменьшение степени которого свидетельствует о
благополучном течении воспалительного процесса, а увеличение– вызывает
необходимость различных коррегирующих действий.
Исследование необходимо для решения вопроса о возможности выполнения
отсроченной радикальной операции
41.
ЭНДОРЕКТАЛЬНОЕ УЛЬТРАЗВУКОВОЕ ИССЛЕДОВАНИЕ.Не является обязательным методом обследования, используют для уточнения
диагноза.
УЗ-исследование со стороны промежности и трансректальная сонография
позволяют оценить локализацию, размеры, структуру патологического очага,
наличие дополнительных ходов, степень вовлечения в воспалительный процесс
стенки прямой кишки и волокон наружного сфинктера, глубину расположения
патологического очага от кожных покровов.
Эффективность ультразвукового исследования в определении ОП составляет 80-89%
Точность ультразвукового исследования достигает 90%.
42.
ДИФФЕРЕНЦИАЛЬНЫЙ ДИАГНОЗ.Учитывая особенности клинических проявлений острого парапроктита, в основном
проводят дифференциальную диагностику с :
-нагноившейся тератомой параректальной клетчатки,
-абсцессом дугласова пространства, вскрывшимся в параректальную клетчатку.
Парапроктит так же может являться осложнением распадающейся опухоли прямой
кишки.
43.
ЛЕЧЕНИЕ.Лечение острого парапроктита только хирургическое.
Операция должна быть выполнена в ближайшие часы после верификации
диагноза. Промедление с операцией не только ухудшает состояние
больного, но и отягощает прогноз, т.к. чревато опасностью распространения
гнойного
процесса по клетчаточным пространствам таза, разрушения мышечных
структур сфинктера и тазового дна, стенки прямой кишки.
Хирургическое лечение может быть как радикальным
одномоментным, так и многоэтапным. Наиболее целесообразно
разделение хирургического лечения на несколько этапов.
На первом из них производится неотложное вскрытие гнойника, на
втором – ранние отсроченные радикальные операции, осуществляемые 5-7
дней спустя, после полного стихания воспалительных явлений.
Цель – вскрытие и дренирование гнойника, поиск и ликвидация
пораженной крипты и гнойного хода .
44.
МНОГОЭТАПНЫЙ ПОДХОД К ЛЕЧЕНИЮ ОСТРОГО ПАРАПРОКТИТА.Наиболее целесообразный и оправданный метод лечения острого парапроктита.
Основные хирургические принципы первого этапа:
• выполнение оперативного вмешательства в возможно ранние сроки;
• широкое вскрытие подкожного гнойника для обеспечения достаточного оттока
гнойного содержимого и адекватное дренирование гнойной полости;
• обеспечение интактности волокон анального сфинктера при ликвидации
абсцесса;
• исключение применения скальпеля при манипуляциях в глубине раны;
• выполнение различных действий в просвете гнойной полости только под
контролем введенного в прямую кишку пальца другой руки;
• обязательное вскрытие и адекватное дренирование основного гнойного очага, а
не только воспалительного фокуса в подкожной клетчатке .
45.
РАДИКАЛЬНЫЕ ОПЕРАЦИИ ПРИ ОСТРОМ ПАРАПРОКТИТЕПоказаниями к радикальному оперативному лечению пациентов с остром
парапроктитом являются:
1. четкое представление о локализации гнойника, гнойного хода и пораженной
крипты,
2. относительная интактность окружающих гнойный очаг тканей.
Противопоказанием к проведению радикальных операций являются:
1. Невозможность определения пораженной крипты,
2. тяжелое соматическое состояние пациента,
3. выраженные воспалительные изменения тканей в зоне предполагаемого
оперативного вмешательства.
Включают в себя:
- вскрытие и дренирование абсцесса;
- иссечение пораженной крипты и гнойного хода в просвет кишки.
- сфинктеротомия (межсфинктерный парапроктит)
- проведение эластической дренирующей лигатуры (транссфинктерное или
экстрасфинктерное поражение).
46.
В послеоперационном периоде как после радикального, так и после первого этапамногоэтапного лечения пациентам проводят:
1. Ежедневные перевязки послеоперационной раны с использованием перекиси
водорода, антисептиков на йодной (Бетадин, Йодопирон, Йод-повидон и др.) или
спиртовой (Хлоргексидин, Диоксидин) основе.
2. Местное применение мазей ускоряющих репарацию тканей (Метилурацил) и
обладающих антимикробным и противовоспалительным эффектами (Левомеколь,
Левосин, Фузимет) до заживления раны.
3. Комплексное физиотерапевтическое лечение - ежедневные десятиминутные
сеансы УФО облучения, использование воздействия УВЧ в диапазоне 40-70 Вт и
микроволновая терапия в пределах 20-60 Вт.
47.
Хронический парапроктит (свищ заднего прохода, свищ прямой кишки) – этохронический воспалительный процесс в анальной крипте, межсфинктерном
пространстве и параректальной клетчатке, сопровождающийся
формированием свищевого хода. При этом пораженная крипта является
внутренним отверстием свища.
В 30-50 % случаев после острого парапроктита у больных
формируется свищ
прямой кишки.
Свищи прямой кишки
могут быть другой этиологии:
- посттравматические, в т. ч.
послеоперационные;
- Свищи, дренирующие
параректальные кисты;
- Свищи при болезни Крона
48.
Классификация :-полный (есть внутреннее и наружное свищевое отверстие)
-неполный внутренний (есть только внутреннее отверстие)
По локализации внутреннего отверстия бывают:
-задний
-передний
-боковой
В зависимости от расположения наружнего сфинктера выделяют:
-интрасфинктерный
-транссфинктерный
-экстрасфинктерный
Экстрасфинктерные свищи имеют 4 степени сложности:
I – нет рубцов вокруг внутреннего отверстия, нет гнойников и инфильтратов
II-рубец около внутреннего отверстия без воспаления
III –внутреннее отверстие без рубцов, но есть воспаление в клетчатке
IV – внутреннее отверстие широкое с рубцами воспалительным инфильтратом в
клетчатке.
Свищи прямой кишки высокого уровня (расположены выше зубчатой линии в
нижне-ампулярном отделе прямой кишки)
49.
Интрасфинктерные свищи - самые простые свищи, составляющие 25-30% всехсвищей прямой кишки. Также данные свищи называются подкожно-подслизистыми,
краевыми. Свищевой ход, как правило, бывает прямым, рубцовый процесс не
выражен, давность заболевания обычно небольшая. Наружное свищевое отверстие
чаще всего локализуется вблизи от ануса, внутреннее может быть в любой из
анальных крипт.
Транссфинктерные свищи – встречаются наиболее часто, составляют 40-45%. Причем
отношение свищевого хода к наружному жому может быть разным – ход может идти
через подкожную, поверхностную или еще выше – через глубокую порцию.
Экстрасфинктерные свищи – встречаются в 15-20% наблюдений. Свищевой ход
располагается высоко, как бы огибает наружный сфинктер, но внутреннее отверстие
находится в области крипт, то есть ниже. Такие свищи, как правило, образуются
вследствие острого пельвиоректального и ретроректального парапроктита. Для них
характерно наличие длинного извитого хода, часто по ходу свища обнаруживаются
гнойные затеки, рубцы. Нередко очередное обострение воспалительного процесса
приводит к образованию новых свищевых отверстий. Иногда воспалительный
процесс переходит из клетчаточного пространства одной стороны на другую и
возникает подковообразный свищ. Подковообразный свищ может быть и задним, и
передним.
50.
Клиника:-наличие наружнего свищевого отверстия на коже перианальной области;
- выделения из наружнего свищевого отверстия ;
- периодически возникающий болезненный инфильтрат в перианальной области
в области наружнего свищевого отверстия ;
- боли, дискомфорт в области заднего прохода.
51.
Интрасфинктерные свищи - самые простые свищи, составляющие примерно 25-30%всех свищей прямой кишки
Диагностика этого вида свищей достаточно проста: пальпация перианальной
области позволяет определить свищевой ход в подслизистом и подкожном слое,
зонд, введенный в наружное свищевое отверстие, обычно свободно проходит в
просвет кишки через внутреннее отверстие или подходит к нему в подслизистом
слое. Проба с красителем (метиленовым синим) у больных с таким свищем обычно
бывает положительной. Функция сфинктера сохранена. Фистулография и другие
дополнительные методы исследования обычно не требуются.
52.
Транссфинктерные свищи – встречаются наиболее часто, составляют 40-45%. Причемотношение свищевого хода к наружному жому может быть разным – ход может идти
через подкожную, поверхностную или еще выше – через глубокую порцию.
При низких транссфинктерных свищах ход определяется в мягких тканях в виде
плотного тяжа, идущего от наружного свищевого отверстия к передней, задней или
боковой стенке анального канала. Чем выше по отношению к сфинктеру расположен
ход, тем чаще встречаются не прямые, а разветвленные ходы, чаще в клетчатке
обнаруживаются полости затеков, сильнее выражен рубцовый процесс в тканях,
окружающих ход, в том числе и в сфинктере.
53.
Экстрасфинктерные свищиПроба с красителем у данной категории больных не всегда
является положительной, при зондировании определяется
глубокий свищевой ход, чаще всего идущий параллельно
прямой кишке. В область внутреннего свищевого отверстия,
как, правило, конец зонда не проникает.
При транссфинктерных и экстрасфинктерных свищах прямой
кишки обследование больного необходимо дополнять
фистулографией, эндоректальной ультрасонографией, МРтомографией для определения порции сфинктера через
которую проходит свищ, локализации внутреннего свищевого
отверстия, оценки расположения гнойных полостей, а также
для дифференциальной диагностики с другими заболевания
при которых может появляться свищевой ход и свищевое
отверстие.
54.
Диагностика:• Жалобы, анамнез,
• Наружный осмотр перианальной и кресцово-копчиковой
области
• Исследование анального рефлекса
• Пальпация мягких тканей в области свища
• Пальцевое исследование анального канала, прямой кишки
• Зондирование свища
• Проба с красителем
• Аноскопия
• Ректороманоскопия
• Колоноскопия, фистулография
• УЗИ ректальным датчиком
• КТ малого таза
• МРТ
55.
Единственным радикальным методом лечения свищей прямой кишкиявляется хирургический.
Операции в основном плановые
При обострении хроническрго парапроктита с формированием абсцесса –
экстренная операция
Наиболее распространенные виды операций при свищах прямой кишки:
1. рассечение свища в просвет прямой кишки;
2. иссечение свища в просвет прямой кишки (операция Габриэля);
3. иссечение свища в просвет прямой кишки с вскрытием и дренированием
затеков;
4. иссечение свища в просвет прямой кишки с ушиванием сфинктера;
5. иссечение свища с проведением лигатуры;
6. иссечение свища с перемещением слизистой оболочки или слизистомышечного лоскута дистального отдела прямой кишки для ликвидации
внутреннего отверстия свища.
56.
Выбор метода операции определяется следующими факторами:1. локализация свищевого хода по отношению к наружному сфинктеру заднего
прохода;
2. степень развития рубцового процесса в стенке кишки, области внутреннего
отверстия и по ходу свища;
3. наличие гнойных полостей и инфильтратов в параректальной клетчатке

medicine
medicine








